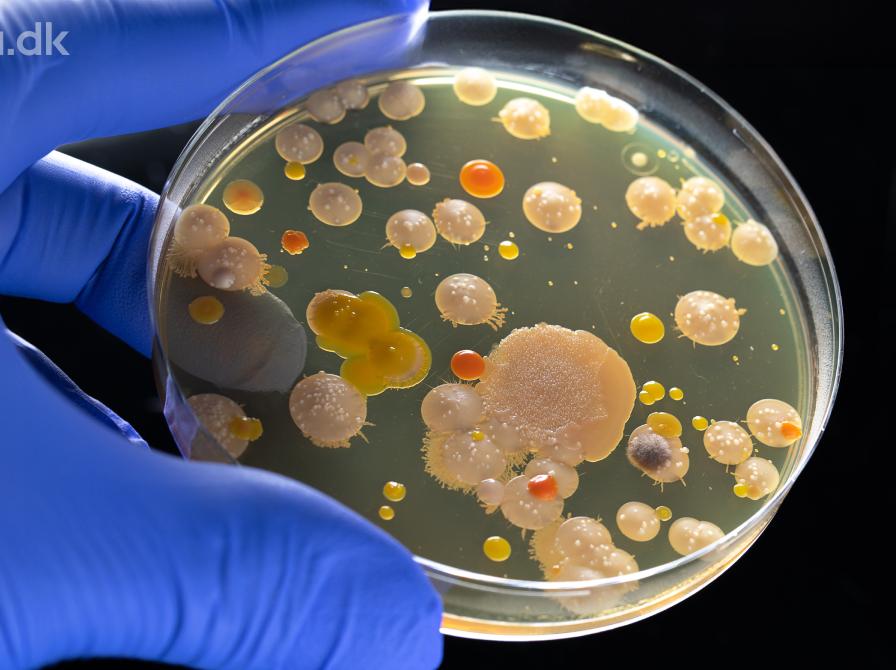

Vil resistente bakterier slå os ihjel? - Livestreamet foredrag fra Aarhus Universitet
- Date
- Udløbet
- Pris
-
standard: Gratis
- Bibliotek
- Marstal bibliotek
- Adresse
-
Prinsensgade 21
5960 Marstal
Danmark
I starten af det 20. århundrede kunne det være dødeligt hvis du fik den mindste skramme og såret blev inficeret med bakterier. Dengang havde vi nemlig ingen effektive midler til at behandle infektioner. Men i 1928 gjorde den skotske bakteriolog Alexander Fleming ved et tilfælde den skelsættende opdagelse af penicillin. Denne opdagelse blev startskuddet til en gigantisk skattejagt efter naturens egne stoffer, der kunne slå bakterier ihjel – lægemidler der i dag kendes som antibiotika.
Indførelsen af antibiotika i patientbehandlingen er et af de største fremskridt i moderne lægevidenskab. Det har betydet, at vi i dag kan behandle de fleste almindelige infektioner, som lunge- og blærebetændelse, og på hospitalerne kan vi udføre store kirurgiske indgreb, organtransplantationer og kræftbehandlinger, hvor adgangen til antibiotika er en nødvendighed. Men hvad er antibiotika, og hvordan virker de?
I dette foredrag vil molekylærbiolog Ditlev E. Brodersen og læge og mikrobiolog Hans Jørn Kolmos fortælle om bakterier og antibiotika. De vil gøre dig klogere på, hvordan de små encellede organismer, bakterierne, ser ud indeni og udenpå, da det netop er bakteriernes opbygning og hvordan de adskiller sig fra menneskeceller, der er grunden til at antibiotika kan slå bakterierne ihjel uden at gøre større skade på os selv. Hør også om de forskellige typer af antibiotika og hvordan de dræber bakterier.
Fremskridtet er dog truet. Bakterierne lærer nemlig hurtigt at udvikle resistens, hvis antibiotikaforbruget bliver for stort, og de kan endda overføre denne resistens imellem sig. Verden over er de resistente bakterier i disse år på fremmarch, og samtidig er udviklingen af nye antibiotika gået i stå. Vi er derfor havnet i en resistenskrise, som kan få store konsekvenser for fremtidens sundhedsvæsen. En dyster prognose siger, at der i 2050 vil dø lige så mange mennesker af resistente bakterier som af kræft, hvis ikke vi for alvor gør noget ved problemet.
Vi ved i princippet godt, hvad der skal gøres: Vi skal begrænse og målrette antibiotikaforbruget i sundhedsvæsenet og i den industrielle husdyrproduktion, vi skal forbedre hygiejnen, og sidst men ikke mindst skal vi udvikle nye antibiotika og metoder til at behandle infektioner. Det vil du høre meget mere om i foredraget. Hør også om den nyeste forskning inden for bakteriernes eget immunforsvar, og hvordan det i fremtiden vil kunne bruges imod dem som et nyt våben i kampen mod de dødelige infektioner.